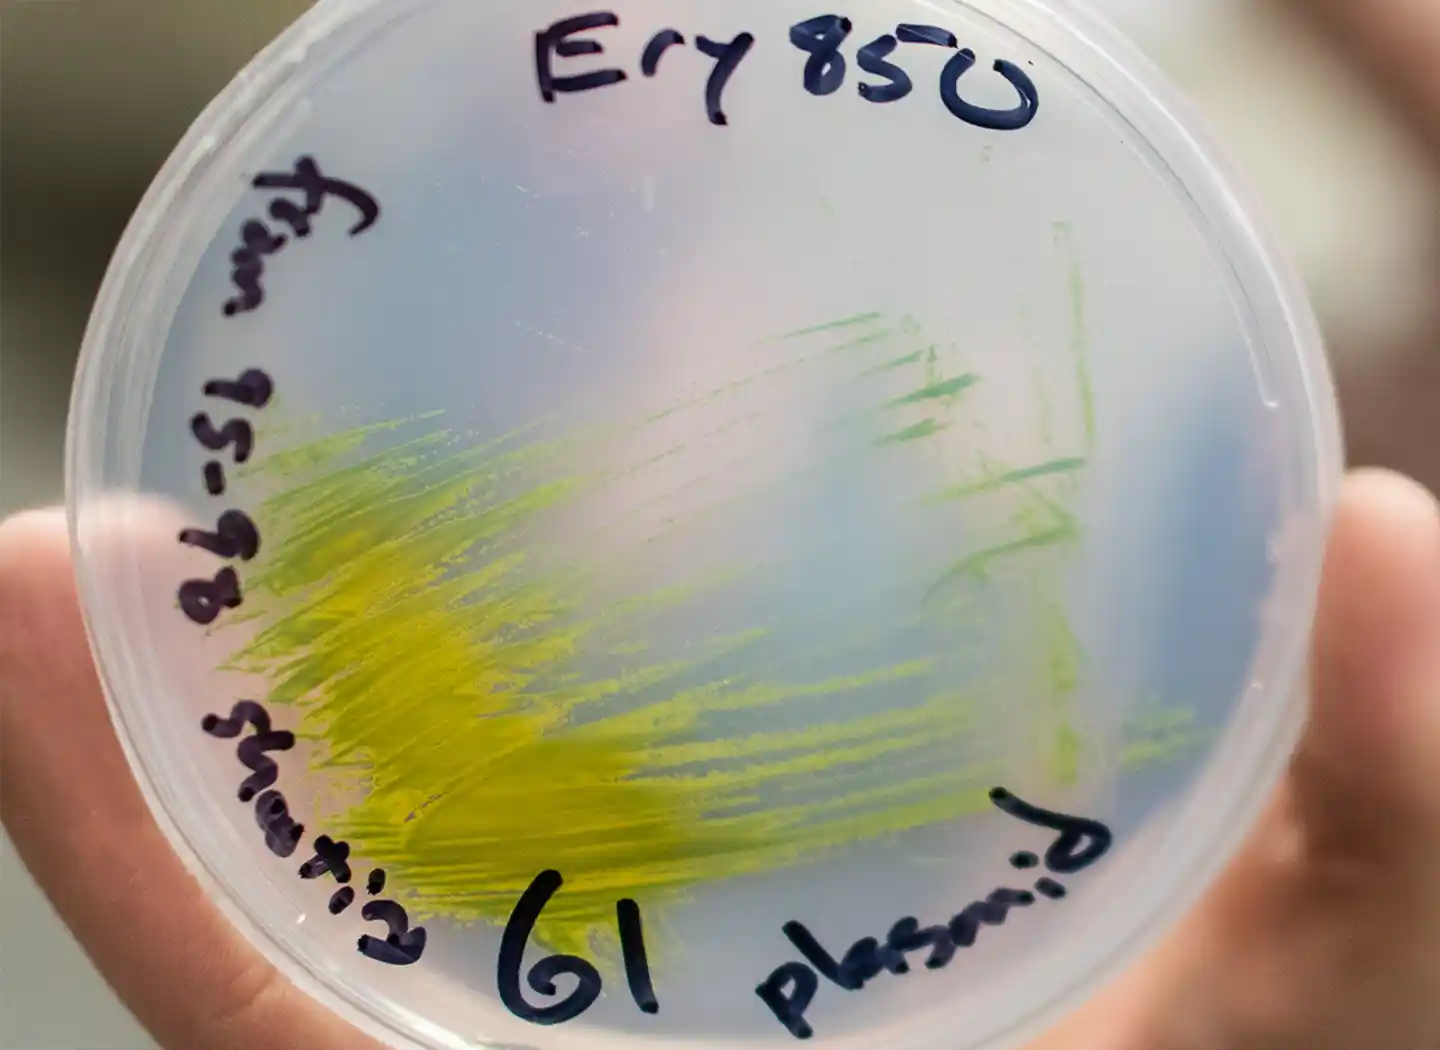
A petri dish held in a hand. The petri dish contains the microalga Picochlorum renovo

Science of Biological Energy Conversion Research
NLR's fundamental science of biological energy conversion research capabilities creates mechanistic understanding that enables control over biochemical and biophysical pathways and processes in living organisms, cell-free, biohybrid, and catalytic systems.

Explore how to partner with us.
Our researchers develop knowledge of matter and energy flows—from molecular to multicellular and organismal scales—that is fundamental to technological innovation and disruption in the bioeconomy. We leverage research capabilities including:
- Cell-free tools and genome engineering for biomanufacturing
- Pathways of electron transfer for catalysis
- Engineering microbes for enhanced biosecurity and fuels and chemical production.
BioImaging Research
Imaging and spectroscopic tools are needed to visualize and probe dynamic cellular processes in plants, algae, and fungi. Through bioimaging research, NLR develops novel chemical imaging systems using enhanced optical and quantum imaging techniques for improved sensitivity and resolution while reducing photo-damage to cells.
Biosystems Design
Systems and synthetic biology approaches enable exploitation of new and model chassis organisms to synthesize natural and unnatural products. Through biosystems design, we create genetic designs for engineering microbial pathways to fuels and chemicals and incorporate strategies for biocontainment and risk mitigation.
Beyond the constraints of intact cells, we discover new biological mechanisms by studying cell-free systems that support enzymatic catalysis to desired products.
Microbial Biotechnology for Biocatalysis and Biosecurity
The IMAGINE Biosecurity strategic focus area establishes a design knowledge base and test platform to achieve predictive control in diverse microbes and enable secure biosystems designs while maintaining optimal performance.
Real-Time Sensing and Adaptive Computing To Elucidate Microenvironment-Induced Cell Heterogeneities and Accelerate Scalability
This "Accelerating Innovations in Emerging Technologies" flagship project predicts microbial performance in large-scale bioreactors by understanding cell population performance, metabolism, and cell-to-cell heterogeneity at the lab scale.
Metabolic Processes, Informatics, and Engineering of Microbial and Plant Systems
Metabolic engineering approaches are used to understand cellular pathways and processes. We probe structure-function relationships for proteins and protein complexes, and other macromolecular components of microbial and plant cells, and explore biosynthetic potential in microbial consortia and plant systems. Learn more about metabolic processes, informatics, and engineering of microbial and plant systems.
Center for Bioenergy Innovation
As partners in the Center for Bioenergy Innovation, led by Oak Ridge National Laboratory, we contribute deep expertise across the biomass-to-biofuels pipeline, including:
- Characterization of biomass feedstocks and variants
- Improvement of deconstruction and conversion technologies in consolidated bioprocessing
- High throughput strain and protein engineering
- Separation and valorization of lignin
- Techno-economic and life cycle analyses.
Pathways of Electron Transfer
Our pathways of electron transfer teams study control of photochemistry and catalysis in diverse enzyme systems to gain a unified understanding of the integration of electron transfer and reduction-oxidation mechanisms in enzyme complexes. The long-term goal is enabling chemical reactions on an industrial scale to occur with minimal energy inputs.
Photosynthetic Energy Transduction
This core program builds understanding of how photosynthesis integrates light capture with enzymatic catalysis to produce reduced compounds.
Mechanism of Photochemical Nitrogen Reduction
This core program discovers how to utilize light capture and electron transfer by nanomaterials for enzymatic reduction of dinitrogen to ammonia.
How NLR's Biological Energy Conversion Capabilities Impact Our Economy
Explore how our fundamental science investigations of matter and energy flows improve bioenergy pathways and processes.
Contact
To leverage these capabilities and expertise or learn more about partnering with us, contact:
Share
Last Updated May 28, 2026